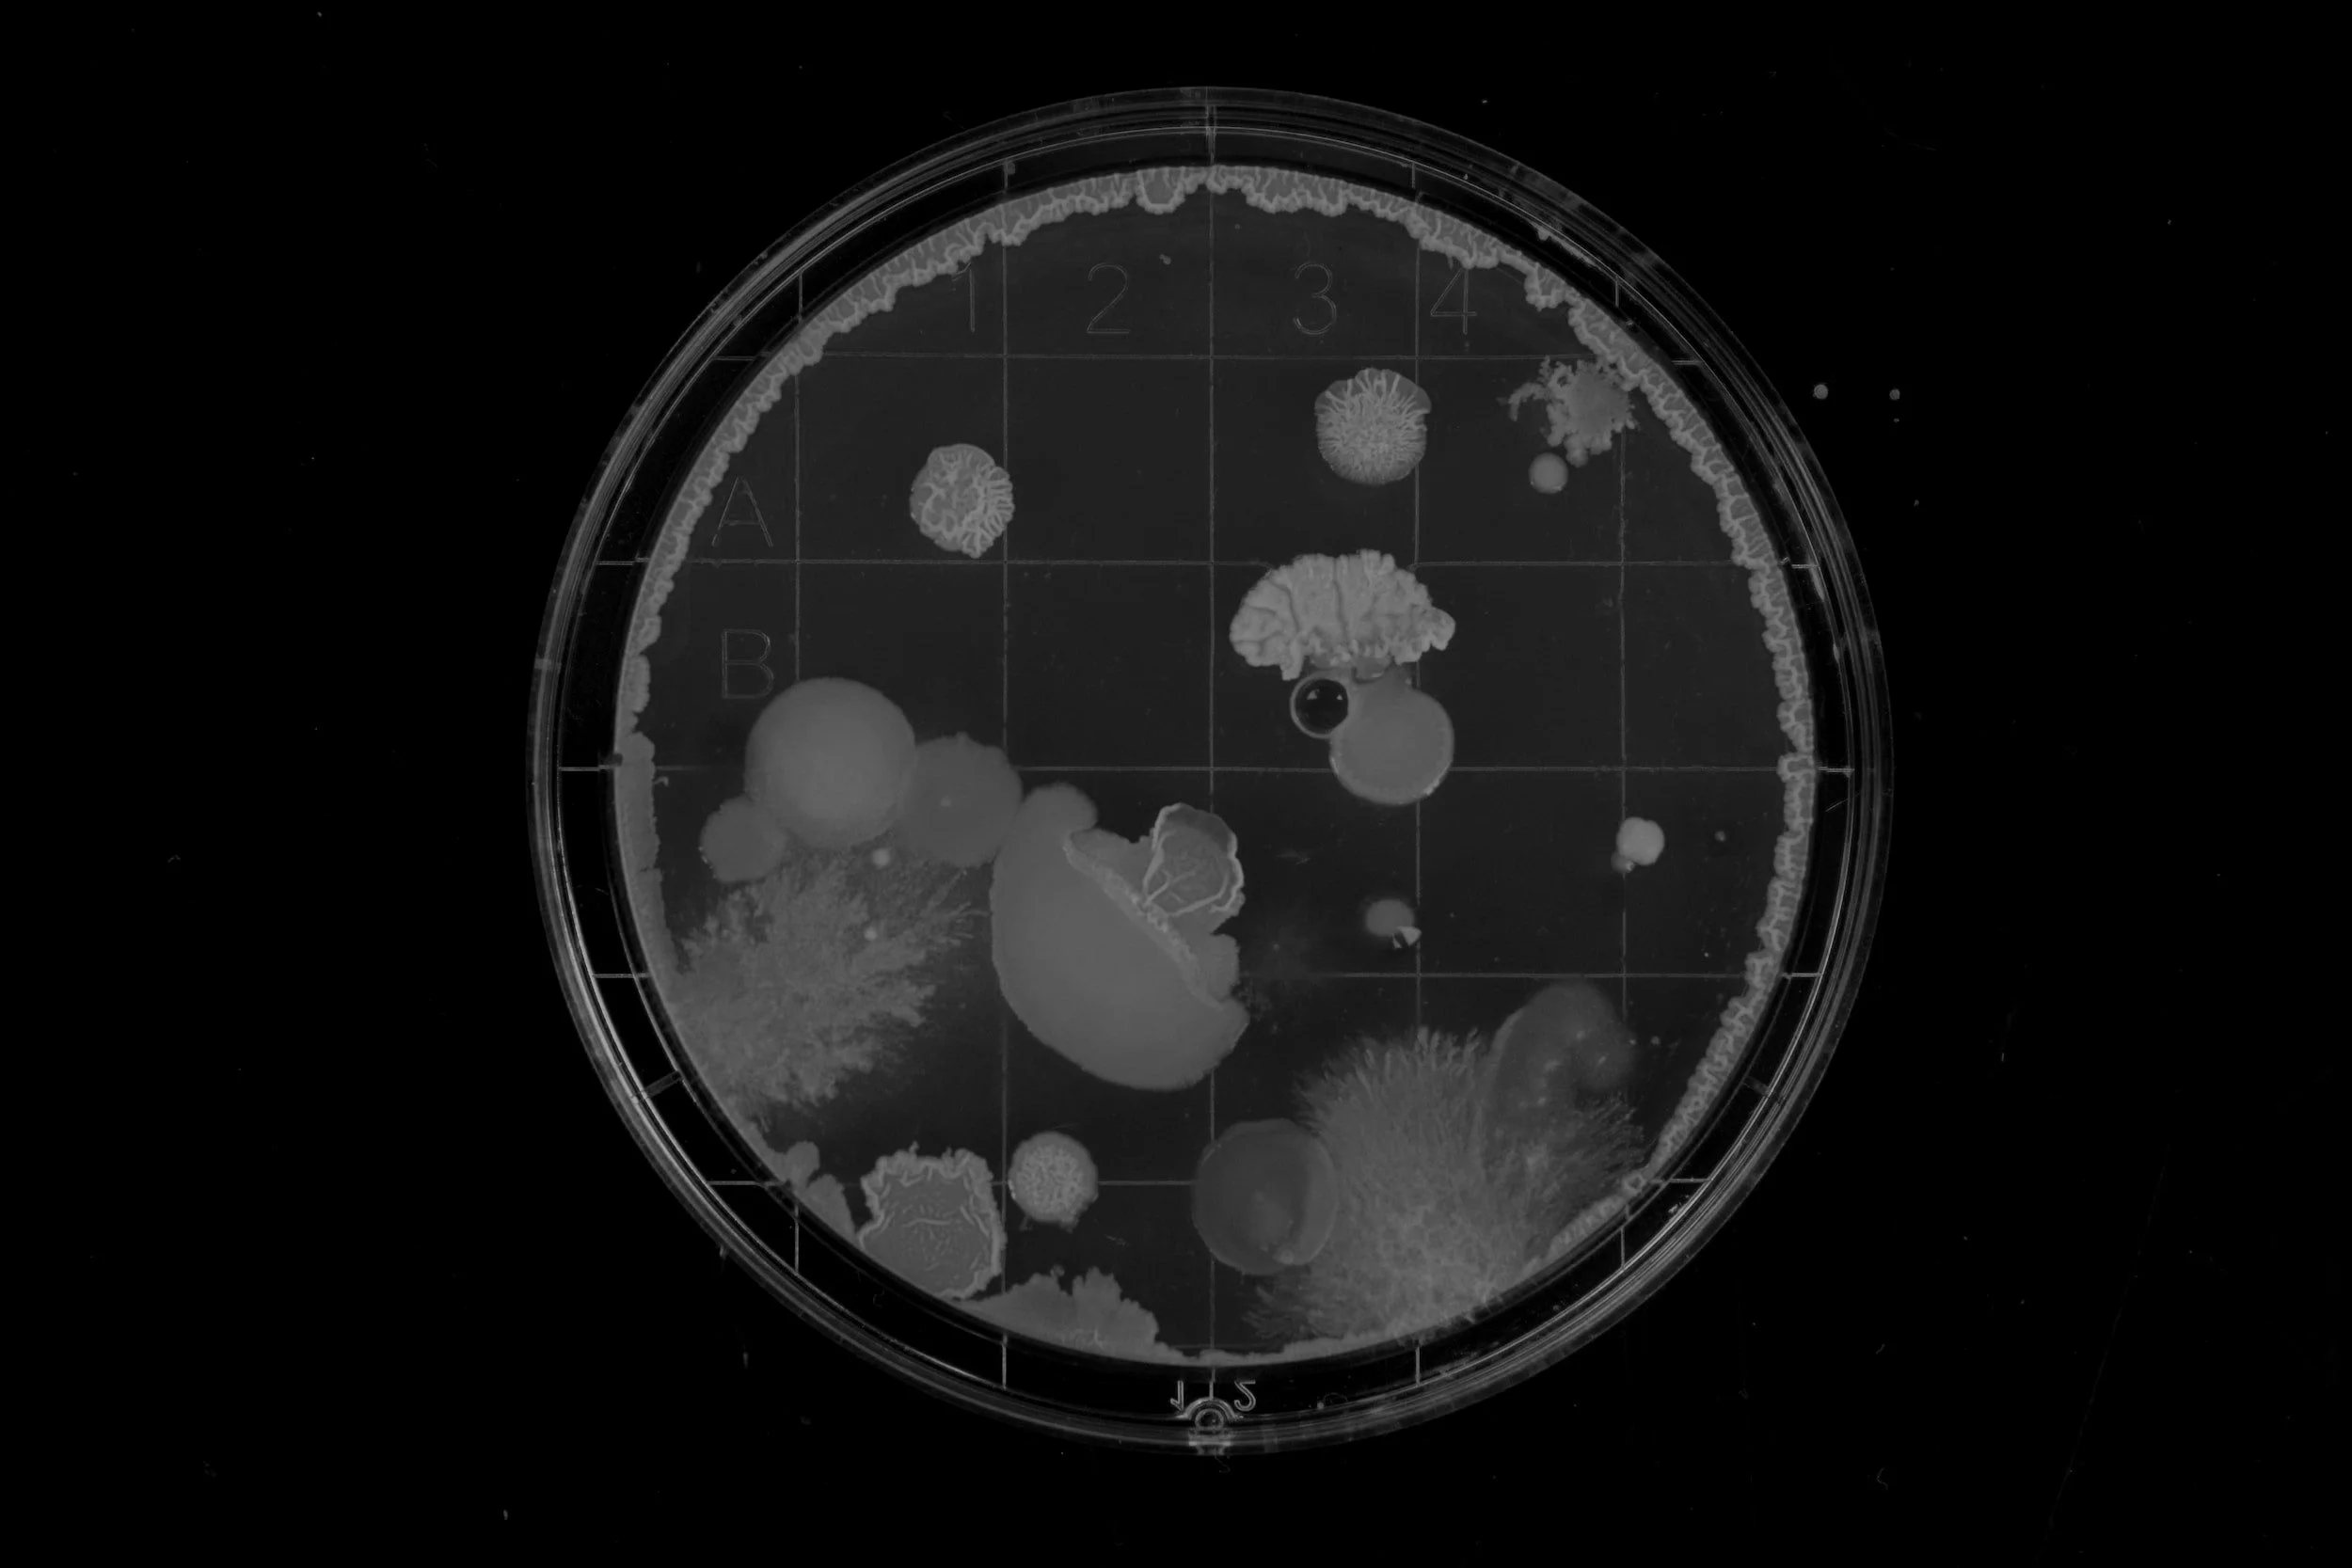

Camden Riley Rowe
Innovator. Entrepreneur. Biotechnologist.
a digital portfolio of my experiences, achievements, and passions.

allow me to introduce myself.

I am a recent Biotechnology Master’s graduate from New York University. My professional interests and experiences lie at the intersection of biotechnology and medicine, with particular focus on neuromodulatory devices, regenerative medicine, and mechanoimmunology. I previously graduated magna cum laude on a full-merit scholarship from New York University, earning my Bachelor’s of Science in Biomolecular Science. Having also completed a pre-medical curriculum, a public health minor, and the MCAT examination process, I intend to use my diverse education for advancing therapeutics and disseminating accurate medical information to the public.
I have been with Ospina Medical, a regenerative medicine practice based in Manhattan, for the past two and a half years. My current, full-time position encompasses two distinct roles that together promote the delivery of cutting-edge and informed care to our patients.
As the Medical Writing Program Manager, I lead a team of 13 medical writers and am responsible for the practice’s medical blog and producing educational yet aesthetic content for patient outreach. This role allows me to leverage my passion for communicating complex medical concepts in a clear and compelling way.
As the Regenerative Medicine and Anesthesia Technician, I administer sedation under an anesthesiologist’s supervision during stem cell and platelet-rich plasma procedures. I am trained in the operation of various medical devices and imaging equipment, as well as in the proprietary lab-processing techniques required for Regenexx procedures. This role has helped me to apply my biotechnology education in a clinical setting.
Outside of my academic and professional pursuits, I am an avid traveler, artist, food enthusiast, and LGBTQ activist. Among my favorite art creations are self-portraits that draw inspiration from the exaggerative styles of Tim Burton. I am currently collaborating with my father, a trained chef, on publishing a cookbook of recipes from around the world, optimized by artificial intelligence.

my digital portfolio
With experiences and an educational background spanning multiple disciplines, I created this website to showcase my unique set of skills and expertise.
Navigation
-
Coursework, Metrics, Content Expertise
-
Experiences, Trainings, Proficiencies
-
Thesis, Research Projects, Lab Skills
-
Scholarships, Awards, Achievements
-
Scholarly Research, Medical Articles
-
Passion Projects, Commissions

portfolio highlights